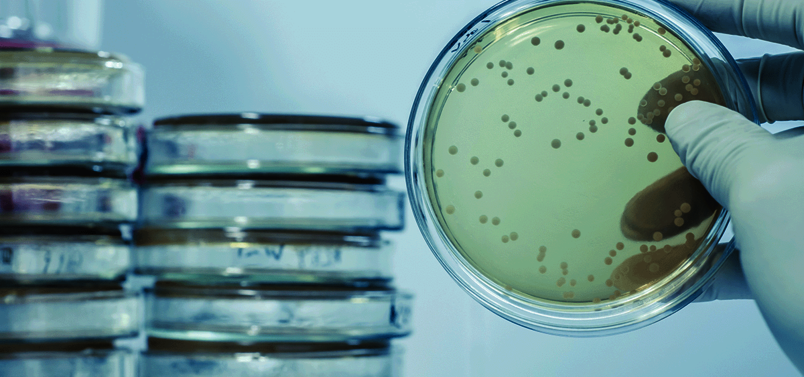

Thermomixers Verwarmen/Mixen
Kies uw beweging


Feiten en cijfers
1500
Max. RPM
1 of 2 blokken
Capaciteit
RT +3 / 130 °C
Temperatuurbereik
± 40 soorten
Blokken

Hettich Benelux Thermomixer V/M
De Hettich Benelux Thermomixers zijn leverbaar met orbitale of lineare schudbeweging van 3 mm en met keuze voor 1 of 2 blokken. De Thermomixers zijn multi-voltage waardoor ze in elk land gebruikt kunnen worden. Optioneel kunnen de units onafhankelijk gekalibreerd worden voor specifieke temperaturen.
Door een dubbelblok model te gebruiken verdubbelt u uw capaciteit en bespaart u niet alleen werkruimte maar ook geld. U kunt twee dezelfde of verschillende (gelijkwaardige) blokken plaatsen tijdens één proces. Accurate temperaturen worden snel bereikt door nauwkeurige temperatuurregeling en aluminium blokken.
Let op: de Thermomixers worden standaard zonder warmteblokken geleverd. Bij een Thermomixer met een capaciteit voor 2 blokken dienen altijd 2 blokken gebruikt te worden.
MHR13 | MHR23 | MHL23 | TH21 | |
|---|---|---|---|---|
| Temp. bereik,°C* | (RT+3) - 130 | (RT+3) - 130 | (RT+3) - 130 | (RT+3) - 130 |
| Max. verwarming, min./°C | 10.1 | 8.5 | 8.5 | 8.5 |
| Mixing frequency, rpm | 200 - 1500 | 200 - 1500 | 200 - 1300 | -- |
| Mix beweging, mm | 3, orbitaal | 3, orbitaal | 3, lineaire | -- |
| Afmeting, cm | 220x330x109 | 220x330x109 | 220x330x109 | 220x330x109 |
| Capaciteit | 1 blok | 2 blokken | 2 blokken | 2 blokken |
| Mixen | x | x | x |
|
| Bestelnr. |
|
|
|
|
* Gemeten met blok 800011000
Voordelen
Applicaties

Voorbeelden:
- Tropische geneeskunde entomologie
Zoö-morfologie, parasitologie

Voorbeelden:
- Analyse van weefselpreparaten, celmateriaal, eiwitniveau of DNA-polymorfismen
- Moleculaire fysiologie en genetica-onderzoek
- Tropische geneeskunde entomologie
- Celtherapie en immunologie
- Organische chemie/biomoleculaire chemie
Zoö-morfologie, parasitologie, celbiologie

Voorbeelden:
- Analyse van weefselpreparaten, celmateriaal, eiwitniveau of DNA-polymorfismen
- Moleculaire fysiologie en genetica-onderzoek
- Tropische geneeskunde entomologie
- Celtherapie en immunologie
- Organische chemie/biomoleculaire chemie
- Zoö-morfologie, parasitologie, celbiologie
Voorbeelden:
- Celtherapie
De juiste accessoires/opties voor dit product
Extra netsnoer Europa
Eventueel:
Extra netsnoer Zwitserland, bestelnr. 980000201
Extra netsnoer U.K., bestelnr. 980000301
Bestelnr.: 980000101

Het assortiment aan blokken is groot. Voor meer voorbeelden, kijk bij 'Hettich Blokken"
Maatwerk blokken zijn ook mogelijk.

Downloads
Gebruiksaanwijzingen en EU-conformiteitsverklaringen zijn in de Hettich eIFU-database beschikbaar om te downloaden, specifiek afgestemd op uw apparaat.

Hoe kunnen we u helpen?
Maak uw keuze en stel ons uw vraag.











